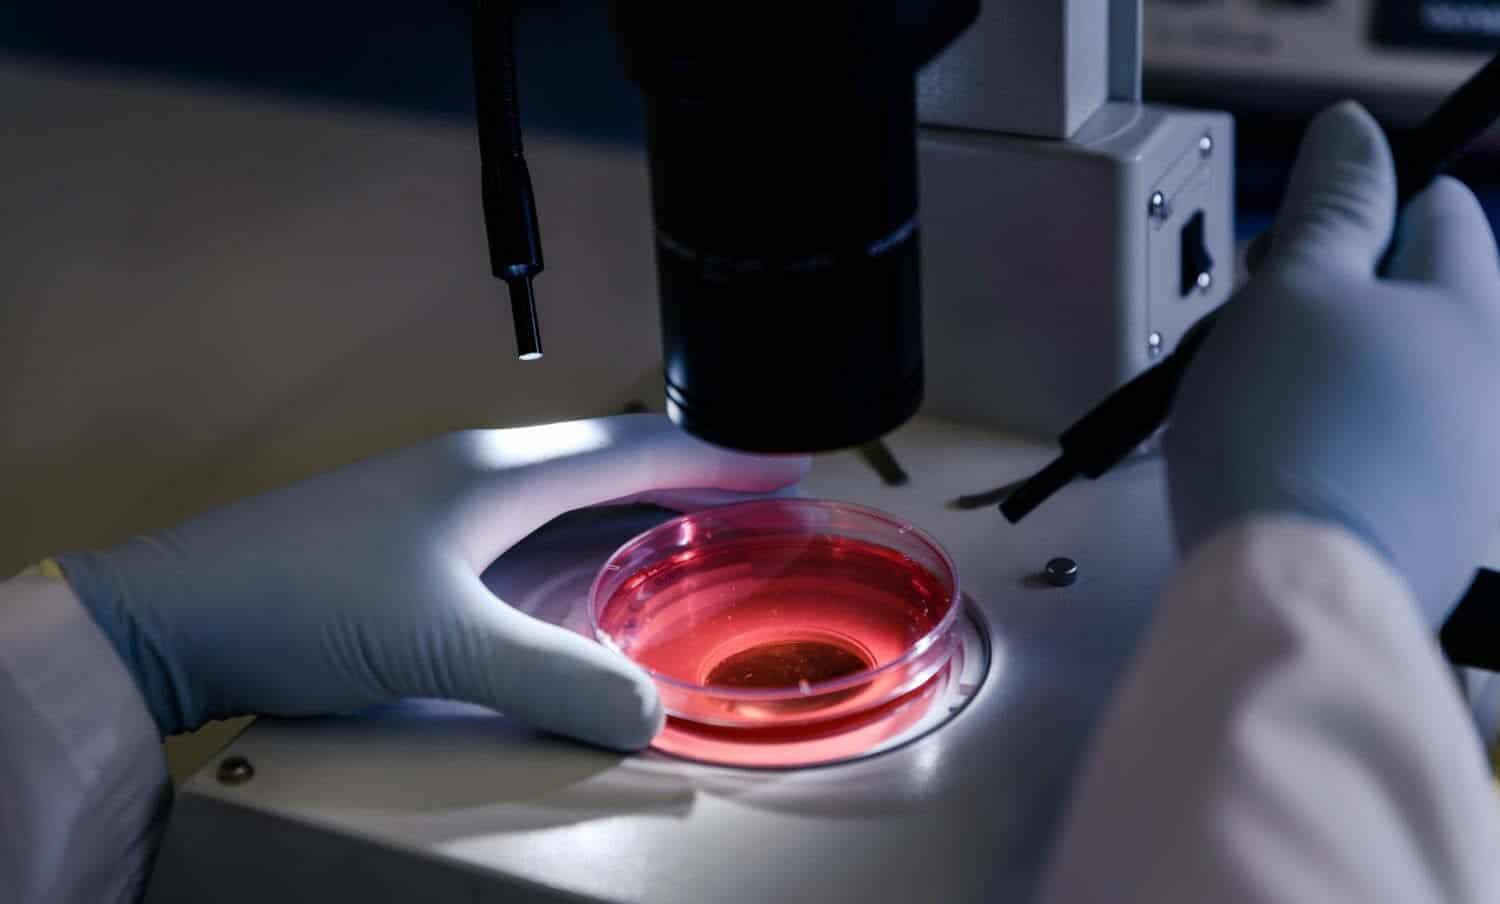

OMS alerta posible propagación de brote del virus de ébola
🚨 Noticias al instante en WhatsApp
Únete GRATIS a nuestro canal y recibe las alertas más importantes antes que todos.
👉 Seguir canal en WhatsAppLa Organización Mundial de la Salud (OMS) advirtió el riesgo de propagación de un nuevo brote de ébola en la República Democrática del Congo, porque el área afectada está muy conectada con la capital y países vecinos.
“Hay que tener cuidado, Mbandaka está muy conectada con Kinshasa, hay que estar alertas y ser vigilantes”, dijo en Ginebra el director de Emergencias Sanitarias de la OMS, Michel Ryan.
El nuevo brote, el cual se declaró este fin de semana, ya causó la muerte de dos personas; mientras que 145 personas que se les considera como “contactos” están bajo seguimiento epidemiológico en la ciudad de Mbandaka.
El doctor Ibrahima Socé Fall, director adjunto para respuestas de emergencias de la organización, comentó que es preocupante que el ébola haya vuelto a detectarse en una zona urbana y con densidad demográfica elevada.
“Hay riesgo de propagación del río hacia países como la República Centroafricana o República del Congo (Brazaville). Por eso estamos trabajando con las autoridades y movilizando a las comunidades, para no perder ninguna cadena de transmisión”, dijo. Ryan sostuvo que empezarán con la inmunización de los grupos de mayor riesgo.
El ébola es una enfermedad altamente transmisible y de elevada mortalidad.
🚨 Últimas noticias en tiempo real
Únete GRATIS a nuestro canal y recibe alertas antes que todos.
👉 Suscribirme en TelegramTAMBIÉN PUEDES LEER: Falleció el primer niño por la nueva hepatitis aguda infantil que ya está en 11 países





